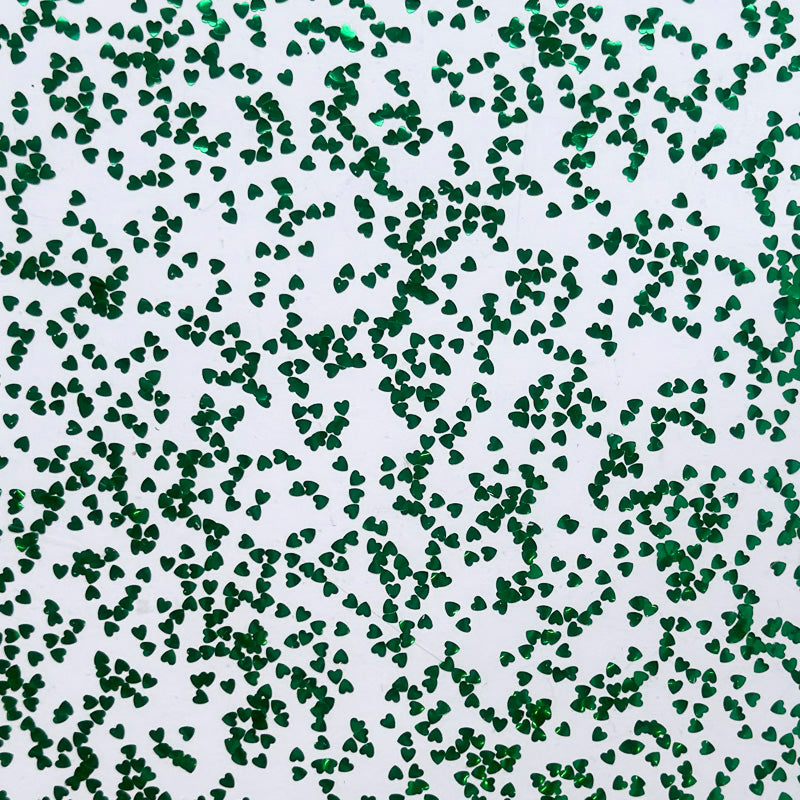

3mm thick transparent glossy acrylic with emerald green heart shaped sequins confetti.
This material is so jazzy and fun! It's perfect for sparkly jewellery, exciting displays and other creative uses. As the sheet is transparent, the glitter is visible from both front and back.
Available in a range of stunning colours.
This stunning luxury acrylic is suitable for many types of fabrication, including laser cutting, engraving, sawing, drilling, bending and thermoforming.
All sheet sizes/ thicknesses are nominal/ approximate. As with all cast acrylics the thickness can vary slightly across the sheet due to the manufacturing process. There may be some slight surface texture on one side (but rarely noticeable).
If you would like your own designs laser cut on this material, or to purchase sheet sizes not listed or sold out products please send us an email to info@sketchlasercutting.co.uk
We can ship internationally, please contact us for a quote.